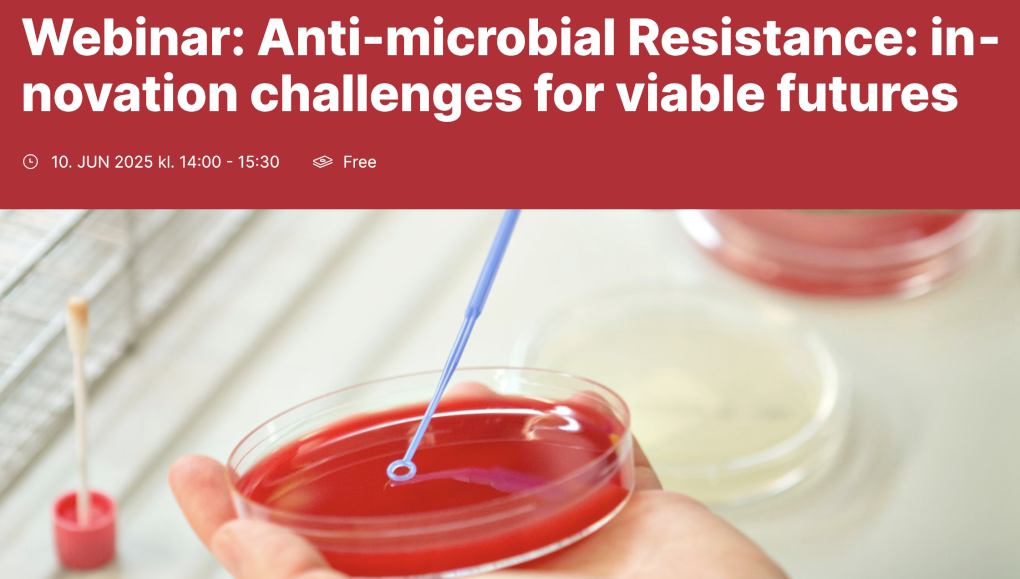
GPSS Series on Antimicrobial Resistance: Innovation Challenges for Viable Futures

Wells, N., Alas Portillo, M. Y., Paterson, E. L., Vagneron, F., & Kirchhelle, C. (2025). Historicising the “Empty Pipeline”: How Antibiotic Innovation Became a Market Failure (1980–2024). Public Humanities, 1, e163. https://doi.org/10.1017/pub.2025.10067
Blog
-

Christian Haddad presents work at EISAPEC-2025
27.08.2025
ALTERBIOTIC PI Christian Haddad chaired a panel entitled ‘Shifting infrastructure of/for/in Global health: broken, emergent, reconfigured’ as part of the European International Studies Association Pan-European Conference (EISAPEC25) in Bologna, August 26-29, 2025.
The panel investigated how infrastructures evolve, adapt, and transform in response to shifting global health challenges, and how these changes, in turn, impact the infrastructures themselves.
Christian contributed a paper that reports ongoing research from ALTERBIOTIC, asking how the antibiotic R&D ecosystem should be considered a vital global health infrastructure. -

ALTERBIOTIC team members join MAE 2025 Conference
17.09.2025
This year saw the Medical Anthropology Conference Europe arrive in Vienna – an opportunity not to be missed by the ALTERBIOTIC team. The conference brought together researchers from across Europe and beyond, to discuss how shifting definitions of health and wellbeing are shaping medical practices, policies, and everyday life.
ALTERBIOITIC’s Kirstin Bentley joined the conference with an open eye to ongoing anthropological work on themes relevant to ALTERBIOTIC – here is Kirsty’s digest:
Medical Anthropology as a discipline provides a powerful lens through which to examine how health and wellbeing are understood and experienced across different cultural and social settings. This perspective is important for understanding antimicrobial resistance, which goes beyond biology and medicine to involve social influences and changes in behaviour.
Kirsty’s highlights of the conference were the talks, “The Microbiome Multiple”, which tracked the manufacture story of the microbiome, and “Medical anthropologists in global ‘One Health’ assemblages”, wherein key insights were provided into the adoption of the One Health scheme in Kenya, Sierra Leone and Switzerland.
Kirsty also partook in a laboratory session, “Sensory Engagements with Microbes”, led by César Giraldo Herrera, which offered a thoughtful rethinking of human-microbe relations through sensory practices such as vision – challenging participants to question notions of ‘objective vision’ and what is deemed as ‘scientific’, ‘truthful’, or ‘neutral’ observation.
We look forward to more fruitful discussions with scholars in the field of Medical Anthropology and thank the organisers and speakers for an interesting and insightful few days!
-
GPSS Series on Antimicrobial Resistance: Innovation Challenges for Viable Futures
10.06.2025
As part of the Global Pharmaceutical & Society Studies (GPSS) webinar series, Christian Haddad presented the ALTERBIOTIC project and its key research objectives, alongside a thorough conceptualization of the antibiotic innovation crisis. Social science research – and especially perspectives form Science & Technology Studies (STS) — are indispensable to grasp this crisis, as pharmaceutical innovation are not just technical issues to be fixed by technical means, but are embedded in broader social, cultural, economic and institutional regimes and frameworks.
Alongside Christian were fellow speakers Dr Rohit Malpani, senior advisor to the Global Antibiotic Research and Development Partnership (GARDP), and Dr Vasanthi Ramachandran, Vice President of BUGWORKS Research India.
Dr Malpani discussed the discrepancies between framing the AMR crisis as a public health, or as an innovation failure, highlighting the real-world impact of public-private partnerships like GARDP in reshaping the innovation landscape. Meanwhile, Dr Ramachandran provided a glimpse into the research conducted at BUGWORKS – including the use of cutting-edge AI technology to revolutionise drug discovery – reflecting on the pivotal role of small companies in addressing the AMR crisis. Main challenges persist for small companies in the need to diversify funding partners and collaborators.
-
Research
Conceptual Perspective
Conceptually, ALTERBIOTIC integrates research perspectives from distinct fields, including critical innovation studies, science and technology studies, political economy of pharmaceuticals, and social studies of microbes. Combined, these diverse approaches provide theoretical and analytical sensibilities to guide the research process and to make sense of different aspects and dimensions of alter-biotic innovation processes.
On this basis, the project coins and develops the concept ‘alter-biotic innovation’ to investigate the politics of antimicrobial innovation initiatives, and the kinds of social, technical and political alternatives to incumbent regimes of antibiotic development they envision and build. The ‘alter’ in alter-biotic comprises at least the following dimensions:
- to bring into view, map and jointly conceptualize the highly diverse set of articulations, visions and practices which have in common that they, in one way or another, problematize and aim to overcome the limitations of antibiotic drug discovery, development and deployment regimes
- to facilitate an empirical analysis of the diverse, and often contending, visions and practices that different actors pursue as alternatives to existing antibiotic regimes
- to compare and contrast the many competing ‘alter-biotic’ approaches and to examine the key differences between them and how they diverge from incumbent/traditional antibiotic regimes
- to theorize the deeply political dimensions of alter-biotic innovation, by investigating the technopolitical and biopolitical implications of AMR crisis and the kinds of alternative futures co-developed with alter-biotic innovation practices
Under this conceptual umbrella, ALTERBIOTIC investigates the practical tensions and challenges of current innovation initiatives and re-connects these practical issues with conceptual problems of social and political theory!
Methodology
ALTERBIOTIC is an empirically driven, qualitative social science research project that employs a comparative case study approach informed by interpretive methodologies and ethnographic sensibility. This enables the project to engage closely with actors, capture their situated experiences, and analyze the complexities of the field in which they operate, its diverse practices, as well as the tacit assumptions, values and future visions that animate it.
ALTERBIOTIC gathers data in a fieldwork-driven research process that deploys several methods including conference and event ethnography, qualitative expert interviews and practice-based document analysis. This engagement enables a deep, comprehensive understanding of alter-biotic innovation and its main actors, (competing) objects, discourses, and institutional arrangements.
Research Ethics
ALTERBIOTIC research is conducted in full compliance with national and European legislation, in particular the GDPR and the European Code of Conduct for Research Integrity (ALLEA).
The project engages closely with diverse actors in the antimicrobial innovation field — including scientists, industry representatives, policymakers, and NGOs. Building trustful relations with actors in the field through interaction and dialogue at various sites and occasions is essential for understanding this complex landscape and generating meaningful research outputs. ALTERBIOTIC understands ethnographic sensibility as a commitment to critically reflect the positionality of the team in the field to anticipate, evaluate and mitigate potential bias due to epistemic selectivity and power relations that may occur at various stages in the research.
-
Kaushik Sunder Rajan
Kaushik SUNDER RAJAN is Professor of Anthropology and Social Sciences, and Co-Director or at the Chicago Center for Contemporary Theory, University of Chicago, Illinois. His expertise includes the global political economies of pharmaceuticals and the life sciences, multi-situated ethnography, and critical social theory




